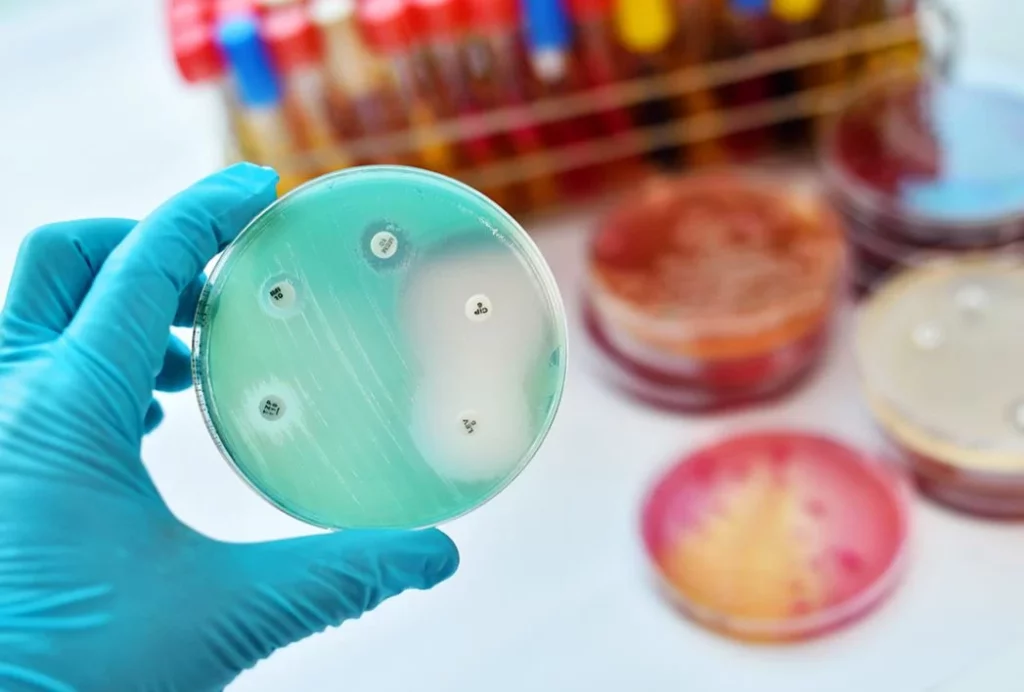
Estrategias efectivas para evitar la resistencia a los antibióticos 1 Moncloa ¿Cómo evitamos la resistencia a los antibióticos?
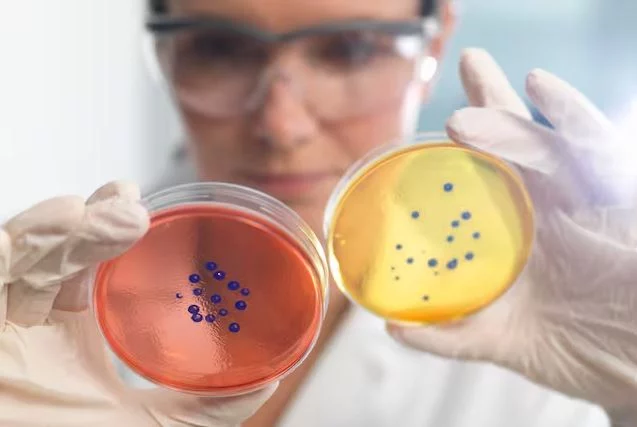
Estrategias efectivas para evitar la resistencia a los antibióticos 2 Moncloa Las medidas que pueden evitar resistencia a los antibióticos

En la actualidad, la resistencia a los antibióticos se ha convertido en un problema que amenaza la salud pública a escala internacional. Es cierto que este tipo de medicamentos son indispensables para combatir las infecciones bacterianas, pero su uso excesivo e inadecuado ha causado que cada vez más bacterias sean resistentes a sus efectos.
Cuando la resistencia ocurre, significa que las bacterias han desarrollado la capacidad de evadir los efectos de los medicamentos y esto imposibilita el tratamiento en los pacientes afectados, lo cual implica un riesgo mortal. Desde el punto de vista de la salud global, esto es una amenaza, debido a que aumenta el riesgo de complicaciones de diversas enfermedades.
¿Cómo evitamos la resistencia a los antibióticos?
Aunque existen muchas medidas que deben tomarse por la autoridades, también existen precauciones que podemos ejercer de forma individual para reducir los riesgos. En primer lugar, es necesario aplicar un uso responsable de los antibióticos, esto significa que solo deben ser tomados cuando el médico los recete y se debe seguir la dosificación indicada. En este sentido, también es esencial no automedicarse, pues puede implicar una mayor probabilidad de desarrollar resistencia e, incluso, empeorar la condición que se esté atravesando en el momento.
Por otra parte, es importante tomar medidas para la prevención de infecciones. Esto implica mantener excelentes medidas de higiene personal y ambiental como lavarse las manos con frecuencia, cubrirse al toser o estornudar, y evitar el contacto con personas enfermas. Llevar una alimentación saludable y tener un estilo de vida activo también es crucial, pues esto es lo que garantizará tener un sistema inmunológico fuerte que reduzca la susceptibilidad a infecciones, así como la necesidad de antibióticos.
Las medidas que pueden evitar resistencia a los antibióticos
Para atacar la resistencia a los antibióticos, las autoridades deben tomar medidas contundentes como la realización de campañas educativas con el fin de concienzar sobre la importancia del uso responsable de estos medicamentos. Además, algunos expertos indican que podría ser necesaria la aplicación de políticas que regulen estos medicamentos.
En este sentido, este problema de salud pública requiere tanto de acciones individuales como colectivas que puedan reducir los riesgos causados por el mal uso de estos medicamentos. De esta forma, la mejor alternativa en la actualidad es aplicar medidas de cuidado en casa y educar a aquellos seres queridos y personas cercanas para reducir los riesgos. Recuerda que la prevención es la mejor manera de cuidar la salud y la calidad de vida.
